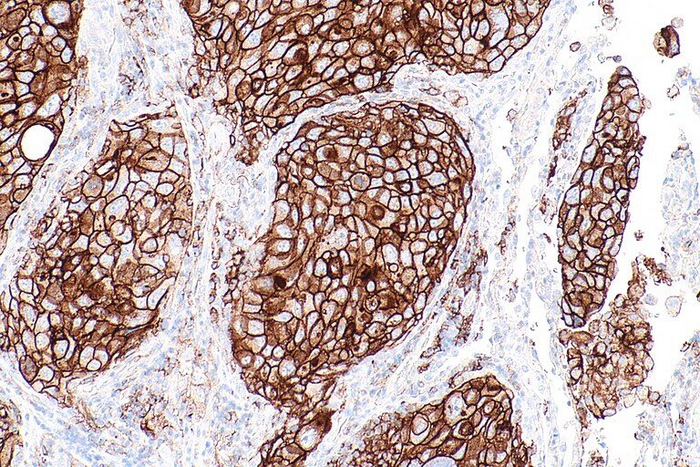

48.
Какая-то дымка и сероватая мгла. Размытый, тускловатый свет. Я в кругу родственников. Идёт обсуждение плана мероприятий. Поднимаюсь наверх, в нашу комнату. Взгляд упирается в разобранную постель, на которой сверху лежит её кофточка. Забиваюсь в угол и начинаю кричать. Некрасиво, противно. Но мне плевать. Слёзы ручьем.
Так мне показали мой первый день без неё. Как будет или как могло бы быть.
Этот сон я увидел на днях, но до сих пор не могу прийти в себя. До чего можно довести психически уравновешенного, здорового мужика! В сны я не очень-то верю. Но здесь я в очередной раз осознал - потеря её для меня неприемлема.
А по сему, борьбу за жизнь супруги, нашу жизнь нужно, необходимо продолжать не смотря на усталость, физическую и душевную боль.
Сегодня, мы переступили трехлетний рубеж, отделивший нас от прошлого, оставивший нам настоящее и перспективу сомнительного будущего.Как это было. Мы жили не тужили, счастливой размеренной жизнью. Подходил тридцатилетний юбилей, когда нас огорошили информацией, что в лёгком(в плевральной полости) супруги скопилось более 2-х л.жидкости. И одной из основных причин этого является онкология.
Наши оперативные действия позволили в кратчайшие сроки выявить причину. Аденокарцинома правого лёгкого, 4-я стадия, с метастазами в лимфоузлы, плевру, кости. Жизнь супруги, в одночасье оказалась на волоске.
Сейчас уже не верится, что в такой короткий срок мне удалось пробить стены нашего здравоохранения и получить лечение, которое оказалось достаточно эффективным. Ведь нам отведены были считанные дни.
И вот три года. Три катастрофически, контрастных года! И хотя трудно было рассчитывать на этот срок в начале нашего пути, всё же, это безумно малый промежуток. Ведь мы планировали счастливо встретить старость вместе. Вдвоём.
Вот и работаем над этим.За это время, эта противная, гадкая и подлая болезнь, ни разу не отступила на длительный срок. Было перемирие, небольшие передышки, но так называемой ремиссии мы пока не дождались. А главное коварство заключается в том, что данная болезнь, в считанные минуты способна сменить чувство эйфории и счастья, отчаянием и неуверенностью. Поднять из глубины, спрятанное силой воли, чувство неизбывной горечи.
Ещё месяц назад мы были полны оптимизма и надежд, а сегодня я отчаянно ищу способ купировать головные боли супруги. Не помогает ничего.
Железный организм, умудряется перерабатывать литры всякой отравы для грядущего блага. Но всему есть предел. После последнего МРТ головы прошло три месяца. Было всё в порядке. Значит произошло критическое накопление токсинов в организме, результатом чего и стали головные боли. Начинаем проводить детоксикацию организма. Самое интересное, что до таких заключений, мы вынуждены доходить своим умом. Ни один врач нам об этом ничего не говорит. В ответ на вопрос только слышим: " что вы хотите? Такое лечение. Побочные явления." Советуют пить обезболивающее.
Очередной курс химиотерапии из 6-ти сеансов мы закончили. Теперь, до победного конца, каждые три недели иммуно+таргетная терапия (Бевацизумаб+ Атезолизумаб). Надо выдерживать. Как я понимаю, ничего другого нам больше предложить не смогут.
Тем не менее, мы живы, относительно активны, и не смотря на подступающую усталость, ещё имеются некоторые силы для борьбы.
А в качестве подведения итогов, скажу следующее:
За это время, мной размещено 48 публикаций описывающих мой взгляд на болезнь близкого, родного человека. Каждый пост просматривают десятки тысяч людей. Думаю, большинство из них, это не праздные любопытствующие. А люди, которых посетила такая неудача. Кто-то находится в начале своего сложного, трудного пути. Пожелаем им удачи, сил и терпения, здоровья и поддержки близких и не очень близких людей.
Знайте, болезнь эта, только Ваша. В том смысле, что зачастую, чужой опыт, прогноз, эффективность лечения, с большой долей вероятности, могут Вам не подойти. Вы индивидуальны, как и Ваша болезнь. Если кто-то приведет пример, как чей-то знакомый или близкий, в таких обстоятельствах сгорел за быстротечный период, к Вам это не имеет никакого отношения.
Один из случаев, например, лекарство используемое при лечении рака предстательной железы, оказалось эффективным при лечении рака лёгкого одного из пациентов. Просто организм позитивно откликнулся на данный вид лечения. А человеку повезло встретить врача-экспериментатора. И да! Есть случаи чудесного исцеления даже при 4-й стадии. Никогда не сдавайтесь. Как бы ни было тяжело. Всем доброго здоровья, оптимизма и удачи!А я пошёл гладить по головочке милочку мою. (Эх! Можно было бы отдать ей свою голову, чтобы избавить от мучений)))